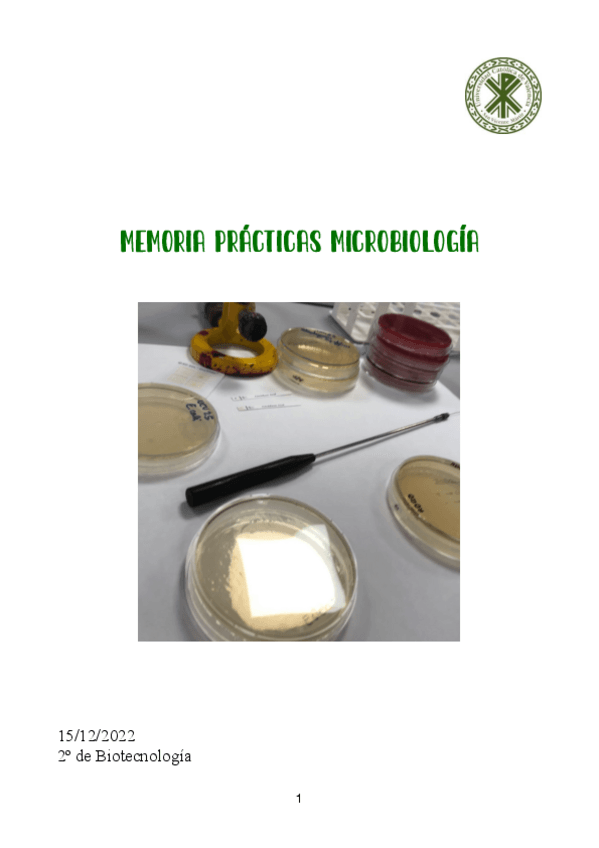

Microbiología
He publicado nuevos apuntes de 4º Microbiología: Preguntas-y-respuestas-T8.pdf
apuntes
-
Microbiología
He publicado nuevos apuntes de 4º Microbiología: Microbiología
He publicado nuevos apuntes de 4º Microbiología: TRABAJO-MICROBIOLOGIA-ARCHAEA.pdf
He publicado nuevos apuntes de 4º Microbiología: TODOS-LOS-TEMAS.-MAPA-METAL-RESUMEN.pdf
He publicado nuevos apuntes de 4º Microbiología: Microbiologia-copy-4.pdf
He publicado nuevos apuntes de 4º Microbiología: Microbiologia-copy-2.pdf
examenes
-
PREGUNTAS EXAMEN PRACTICO
He publicado nuevos examenes de 4º Microbiología: PREGUNTAS EXAMEN PRACTICO
He publicado nuevos practicas de 4º Microbiología: Memoria-practicas-microbiologia.pdf
He publicado nuevos apuntes de 4º Microbiología: 1resumenes-temas-35679.pdf
He publicado nuevos apuntes de 4º Microbiología: micro-apuntes-completos.pdf
apuntes
-
Micro
He publicado nuevos apuntes de 4º Microbiología: Micro
He publicado nuevos apuntes de 4º Microbiología: Cuaderno-Microbiologia.pdf
apuntes
-
Apuntes Microbiología 2023
He publicado nuevos apuntes de 4º Microbiología: Apuntes Microbiología 2023
apuntes
-
todos los powers
He publicado nuevos apuntes de 4º Microbiología: todos los powers
apuntes
-
powers clase
He publicado nuevos apuntes de 4º Microbiología: powers clase
practicas
-
PRACTICAS
He publicado nuevos practicas de 4º Microbiología: PRACTICAS
He publicado nuevos apuntes de 4º Microbiología: cuaderno-practicas.pdf
apuntes
-
Temario microbiología resumido
He publicado nuevos apuntes de 4º Microbiología: Temario microbiología resumido

¡Estás al día!
Has visto todos los archivos